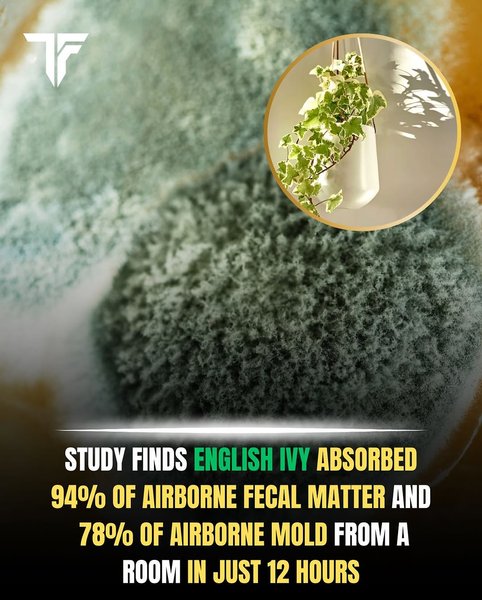
Thumbnail of www-instagram-com-p-dmdtokdo1l5 0

Sublime
An inspiration engine for ideas
@GuruAnaerobic He must have at a salad and the phytotoxins got him, sign up for my special detox program
JackedBasedMgrx.com
Discover recipes, home ideas, style inspiration and other ideas to try.
pinterest.comCyanotoxins have been associated with amyotrophic lateral sclerosis (Lou Gehrig's disease), a fatal neurodegenerative disease.
And Athletic Greens might be loaded with them. 👇
P.D. Mangan Health & Freedom Maximalist 🇺🇸x.com
A 2005 study found that English Ivy significantly reduced air pollutants specifically reducing airborne feces by 94% and airborne mold by 78% within just 12 hours.
English Ivy is also particularly effective at removing formaldehyde, a common indoor pollutant found in building materials, furniture and household cleaning... See more
instagram.comArsenic is another of the chemicals specifically referred to as toxic by the WHO in the Healthy environments report. As discussed in chapter four, arsenic was a main ingredient of insecticidal sheep dips, which, although intended to only kill the insect pest, was shown to have also had a detrimental impact on the health of sheep and sheep farmers,
... See moreDawn Lester • What Really Makes You Ill?: Why Everything You Thought You Knew About Disease Is Wrong
HEAVY METALS DETOX: The Easy Way to Detoxify - Detoxification Helps Protect Against Accelerated Aging, Sickness, Brain Fog, & Fatigue
amazon.com

